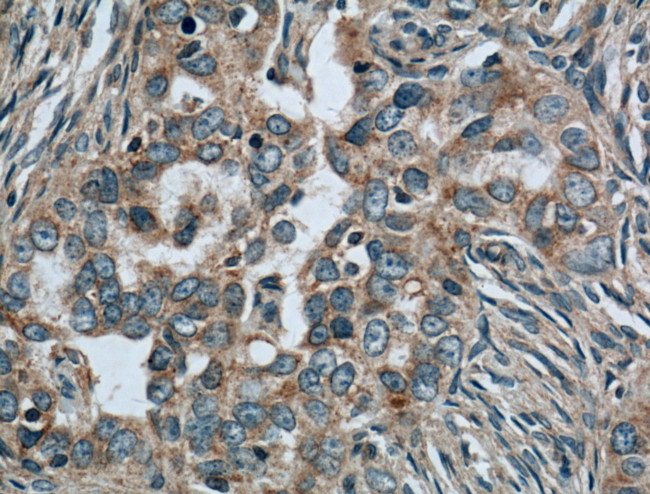
CALCOCO2 Antibody in Immunohistochemistry (Paraffin) (IHC (P))

Search
Proteintech
CALCOCO2 Monoclonal Antibody (2F2C2)
{{$productOrderCtrl.translations['antibody.pdp.commerceCard.promotion.promotions']}}
{{$productOrderCtrl.translations['antibody.pdp.commerceCard.promotion.viewpromo']}}
{{$productOrderCtrl.translations['antibody.pdp.commerceCard.promotion.promocode']}}: {{promo.promoCode}} {{promo.promoTitle}} {{promo.promoDescription}}. {{$productOrderCtrl.translations['antibody.pdp.commerceCard.promotion.learnmore']}}



Please note: We are reviewing Western blot images included in the antibody testing data in our catalog, including those provided by third parties. Unless expressly labeled or annotated as “raw-unedited”, Western blot images included in the antibody testing data in our catalog may have been edited, optimized or otherwise adjusted for presentation.
Product Details
66401-1-IG
Species Reactivity
Published species
Host/Isotype
Class
Type
Clone
Immunogen
Conjugate
Form
Concentration
Amount
Purification
Storage buffer
Contains
Storage conditions
Shipping conditions
Product Specific Information
Immunogen sequence: MEETIKDPP TSAVLLDHCH FSQVIFNSVE KFYIPGGDVT CHYTFTQHFI PRRKDWIGIF RVGWKTTREY YTFMWVTLPI DLNNKSAKQQ EVQFKAYYLP KDDEYYQFCY VDEDGVVRGA SIPFQFRPEN EEDILVVTTQ GEVEEIEQHN KELCKENQEL KDSCISLQKQ NSDMQAELQK KQEELETLQS INKKLELKVK EQKDYWETEL LQLKEQNQKM SSENEKMGIR VDQLQAQLST QEKEMEKLVQ GDQDKTEQLE QLKKENDHLF LSLTEQRKDQ KKLE (1-283 aa encoded by BC015893)
Target Information
The protein encoded by this gene is a subunit of nuclear domain 10 (ND10) bodies. ND10 bodies are nuclear domains appearing immunohistochemically as ten dots per nucleus. They are believed to be associated with the nuclear matrix on the basis of their resistance to nuclease digestion and salt extraction. ND10 proteins are removed from the nucleus by herpes simplex virus-1 infection and may have a role in viral life cycles.
For Research Use Only. Not for use in diagnostic procedures. Not for resale without express authorization.
Bioinformatics
Protein Aliases: calcium binding and coiled-coil domain 2; Calcium-binding and coiled-coil domain-containing protein 2; Nuclear domain 10 protein 52; nuclear domain 10 protein 52 like 1; Nuclear domain 10 protein NDP52
Gene Aliases: 2410154J16Rik; C77254; Calcoco2; Ndp52; Ndp52l1; RGD1559974
UniProt ID: (Mouse) Q3TKZ6
Entrez Gene ID: (Mouse) 76815, (Rat) 303479

Performance Guarantee
If an Invitrogen™ antibody doesn't perform as described on our website or datasheet,we'll replace the product at no cost to you, or provide you with a credit for a future purchase.*
Learn more
We're here to help
Get expert recommendations for common problems or connect directly with an on staff expert for technical assistance related to applications, equipment and general product use.
Contact tech support